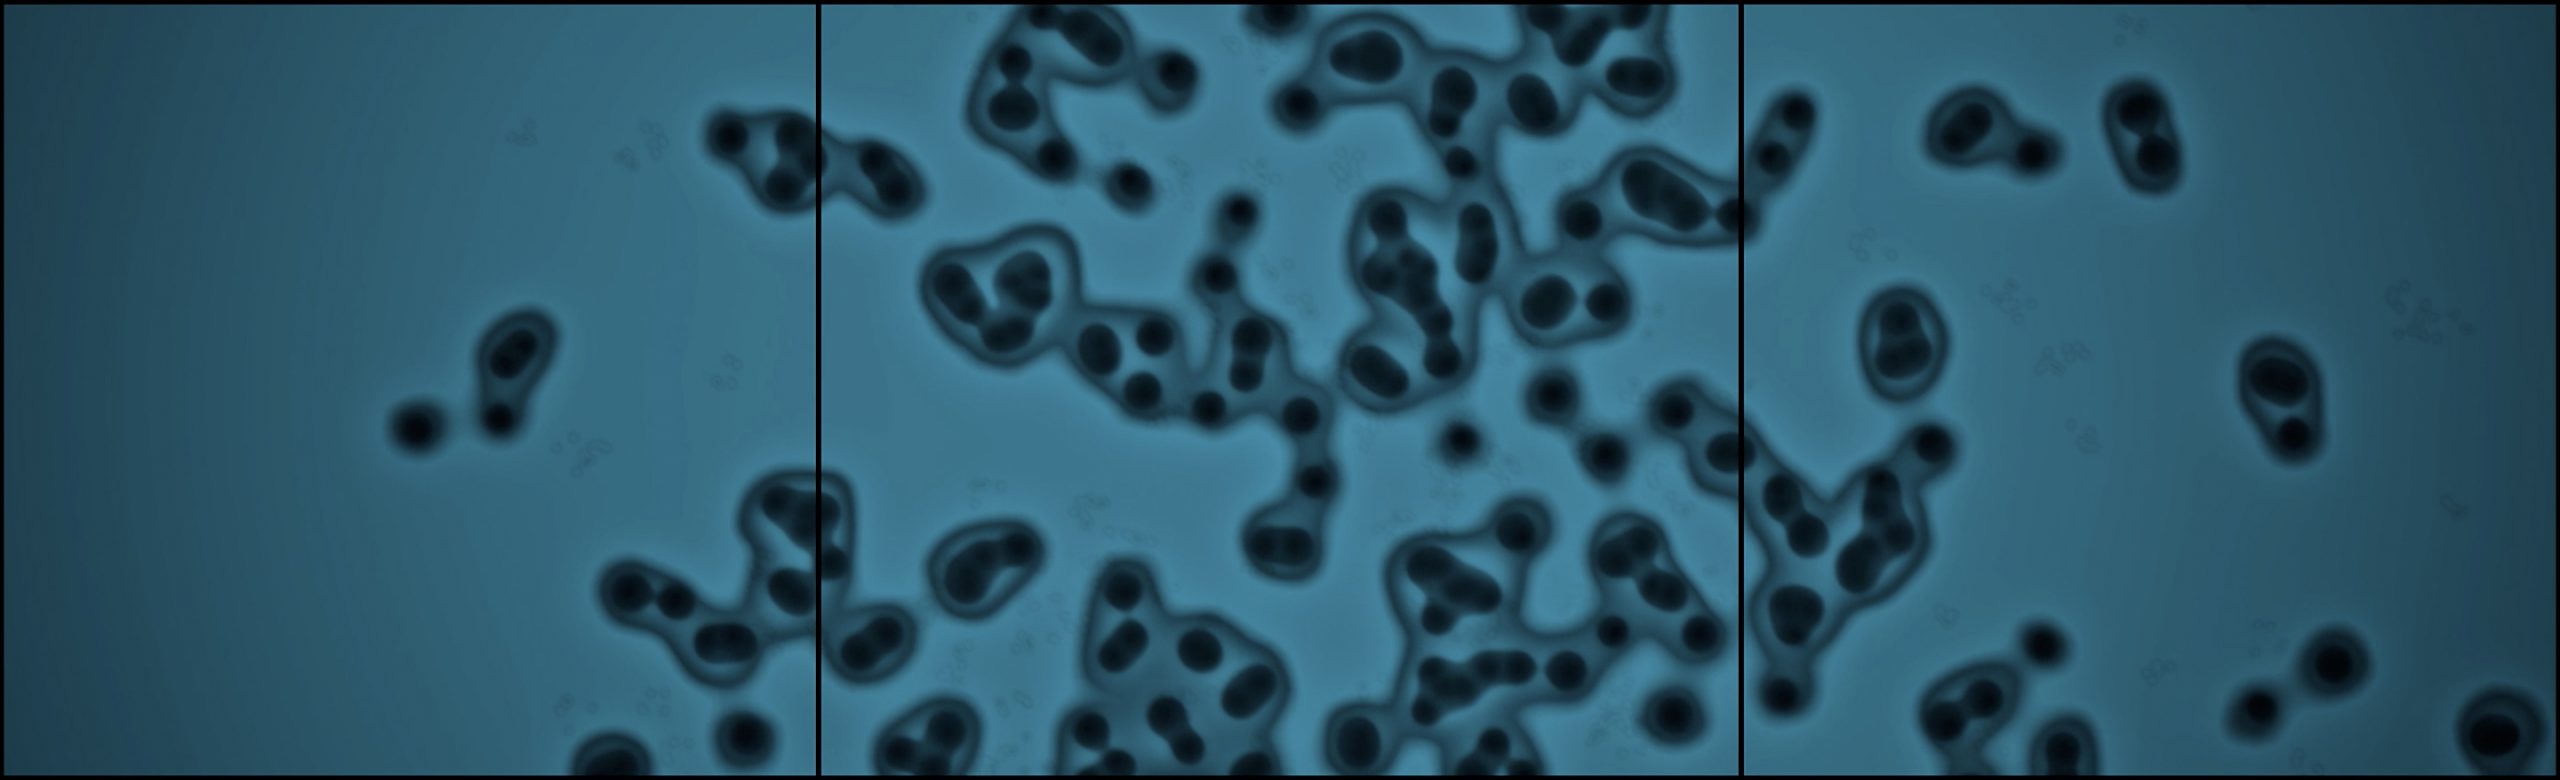

Welcome to the Social Art Award 2025 – Online Gallery!
We are grateful for the many powerful contributions from artists across the globe. The selected works reflect the diversity of contemporary social art practices and address urgent issues such as climate and water crises, social and economic inequality, migration, conflict, discrimination, and the protection of human and more-than-human life.
Below you will find the submissions from the edition of 2024/2025 that passed the initial jury round. The Online Gallery offers public visibility to these works and supports dialogue around their themes; it does not replace the final jury decision.
Thank you to all artists for sharing your inspiring and committed work. We invite you to explore the gallery and engage with the perspectives shaping the Social Art Award 2025.
Arrival
Bodo Korsig
The three-part video installation, Arrival, immerses viewers in a tranquil yet ominous visual realm. The incorporation of spherical underwater sounds and spoken poetry contributes to the unsettling atmosphere of the artwork. Two juxtaposed scenes reveal striking similarities. Smoking chimneys frame underwater environments where plastic bottles contort like a slumbering monster. Arrival highlights the contrast between the Earth's inherent beauty and its increasing degradation due to human interference. The presence of vast amounts of plastic floating in every square kilometer of water and marine animals struggling to survive in polluted habitats underscore this reality. Likewise, we, as humans, find ourselves engulfed in a metaphorical haze, particularly in large cities and urban centers. YouTube video: https://www.youtube.com/watch?v=b1EAZVk8VcI
The three-part video installation, Arrival, immerses viewers in a tranquil yet ominous visual realm. The incorporation of spherical underwater sounds and spoken poetry contributes to the unsettling atmosphere of the artwork. Two juxtaposed scenes reveal striking similarities. Smoking chimneys frame underwater environments where plastic bottles contort like a slumbering monster. Arrival highlights the contrast between the Earth's inherent beauty and its increasing degradation due to human interference. The presence of vast amounts of plastic floating in every square kilometer of water and marine animals struggling to survive in polluted habitats underscore this reality. Likewise, we, as humans, find ourselves engulfed in a metaphorical haze, particularly in large cities and urban centers. YouTube video: https://www.youtube.com/watch?v=b1EAZVk8VcI